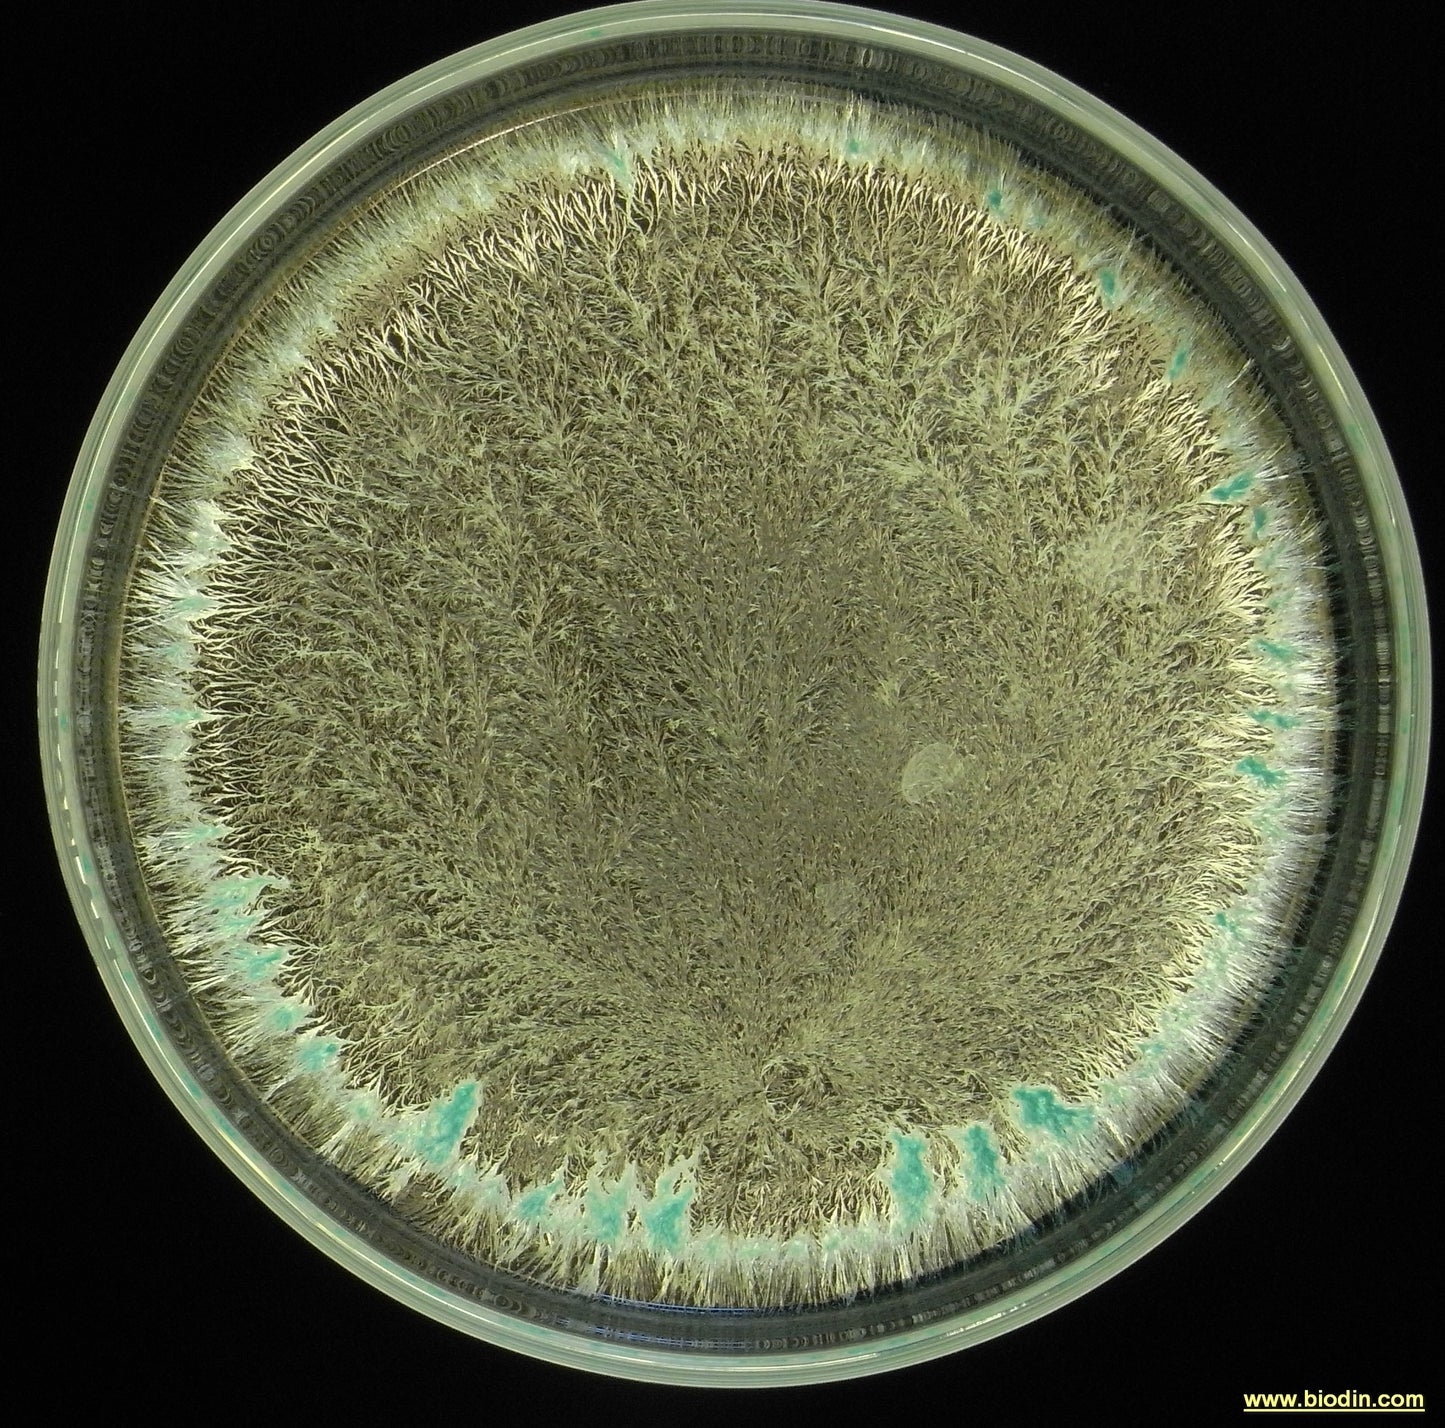

506 DANDELION PREPARATION
Have a question?

506 DANDELION PREPARATION
Dettagli
THE 506 DANDELION PREPARATION
The dandelion preparation or 506 is prepared in June with dandelion flowers inserted into a mesentery of a domestic animal left to ripen in a container with peat in a cool place, extracted and buried at the end of September and ready for use after Easter . I use L. Kolisko's method (see “The agriculture of tomorrow” Agri.Bio Edizioni, method recommended directly by R. Steiner to L. Kolisko after the Koberwitz course). The method usually used instead is to set it up at the end of September and leave it to ripen directly underground until Easter.
This preparation, like all those from 502 to 507, are usually called heap preparations and their use is usually restricted to its preparation, while already from the first experiments of the 1925-30s, experiments had already been carried out for their use single or associated with other biodynamic preparations.
R. Steiner explains that with the action of this preparation the "sulphur relates to the iron" bringing into the compound a process linked to the Moon, the planet that controls growth in vegetables.
These indications that follow are not intended and cannot be exhaustive for the use of the preparation but simply indications that I have grasped with my experience and which I make available to anyone who wants to study, try and experiment and who thinks that biodynamic agriculture is in continuous evolution and not a hard and fast science. It should be noted that the German biodynamic world generally does not use and considers incorrect the use of so-called "heap preparations" for single or non-heap use: consider that many German biodynamicists do not include heap preparations in the Fladen because it does not have said R. Steiner….
• in the 5th Koberwitz Conference R. Steiner states “In order to attract cosmic forces, silicon is necessary and a correct reciprocal action must be created between silica and potassium and not calcium. The plant that, by virtue of its relationship between silica and potassium, is able to transmit this power is the dandelion. It is extraordinarily beneficial to the areas in which it thrives. The substance thus obtained will give the possibility of attracting from the atmosphere and the cosmos as much silica as is necessary for the plant to make it truly sensitive to everything that acts from the environment, and to attract to itself through its own activity what it needs. In order to actually grow, plants must have some kind of sensitivity.
• in his course notes he writes “In the organic process there is a mysterious alchemy whereby if potassium works correctly it is transformed into nitrogen. There is a reciprocal qualitative relationship between carbon and hydrogen which is similar to the relationship between oxygen and nitrogen. Under the influence of hydrogen, carbon and potassium are continuously transformed into elements of a nitrogenous nature: nitrogen must be generated in this way” Much meditation and experimentation needs to be done on this step.
• and he goes on to say “In the organism, silicon is transformed again into a substance that has extraordinary importance and which for now is not yet included among the chemical elements”
• again from the notes of the Koberwitz Course “Salicylic acid activates the fertilizer. The lead makes it such that it is distributed appropriately in the plant
• Mercury and arsenic stimulate life”
• 506 brings the processes of Jupiter (silica) and is related to the forces of Sagittarius (magnesium) and Pisces (chlorine)
• use 506 (15 g) and 507 (25 g inserted in the last 20 minutes) with 501, dynamized and sprayed 25-30 days before harvesting: it enhances colours, shapes, flavours, aromas, taste, crunchiness, degree alcohol and shelf life in the fruit.
• 506 works on flowering and fruiting: it is to be used on plants that have poor flowering
• 506 improves pollen quality, beekeepers should use it a lot
• 506 makes the plant capable of transforming (transubstantiating) light into physical matter
• 506 carries out an opposite action compared to 502: while 502 terrestrialises the plant, 506 cosmicises it.
I remind you that dandelion syrup is available for human use, a syrup with 20% ultrasonic extract that I designed for human use.
Here are its properties: “Liver draining, stimulates the production of bile and the flow towards the gallbladder and intestine. Good diuretic and laxative, it guarantees natural weight loss and benefits in arthritis, making it suitable for obesity and also for metabolic delays. It connects our thinking with the outer planets and brings joviality.” Agri.BioDinamica certified
It is always necessary to check the state of conservation of preparation 506 because it tends to be too humid.
Any other idea or suggestion of yours, experimentation done with the use of 506 would be very welcome to me because only by collaborating and exchanging information are we truly human and we grow and make others grow together.